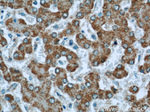
MLYCD Antibody in Immunohistochemistry (Paraffin) (IHC (P))

Search
Proteintech
MLYCD Polyclonal Antibody
{{$productOrderCtrl.translations['antibody.pdp.commerceCard.promotion.promotions']}}
{{$productOrderCtrl.translations['antibody.pdp.commerceCard.promotion.viewpromo']}}
{{$productOrderCtrl.translations['antibody.pdp.commerceCard.promotion.promocode']}}: {{promo.promoCode}} {{promo.promoTitle}} {{promo.promoDescription}}. {{$productOrderCtrl.translations['antibody.pdp.commerceCard.promotion.learnmore']}}
产品信息
15265-1-AP
种属反应
已发表种属
宿主/亚型
分类
类型
抗原
偶联物
形式
浓度
规格
纯化类型
保存液
内含物
保存条件
运输条件
产品详细信息
Immunogen sequence: HHISKLDGG VRFLVQLRAD LLEAQALKLV EGPDVREMNG VLKGMLSEWF SSGFLNLERV TWHSPCEVLQ KISEAEAVHP VKNWMDMKRR VGPYRRCYFF SHCSTPGEPL VVLHVALTGD ISSNIQAIVK EHPPSETEEK NKITAAIFYS ISLTQQGLQG VELGTFLIKR VVKELQREFP HLGVFSSLSP IPGFTKWLLG LLNSQTKEHG RNELFTDSEC KEISEITGGP INETLKLLLS SSEWVQSEKL VRALQTPLMR LCAWYLYGEK HRGYALNPVA NFHLQNGAVL WRINWMADVS LRGITGSCGL MANYRYFLEE TGPNSTSYLG SKIIKASEQV LSLVAQFQKN SKL (142-493 aa encoded by BC000286)
靶标信息
MCD catalyzes the breakdown of malonyl-CoA to acetyl-CoA and carbon dioxide. Malonyl-CoA is an intermediate in fatty acid biosynthesis, and also inhibits the transport of fatty acyl CoAs into mitochondria. Consequently, the encoded protein acts to increase the rate of fatty acid oxidation. It is found in mitochondria, peroxisomes, and the cytoplasm. Mutations in this gene result in malonyl-CoA decarboyxlase deficiency.
仅用于科研。不用于诊断过程。未经明确授权不得转售。
生物信息学
蛋白别名: malonyl coenzyme A decarboxylase; Malonyl-CoA decarboxylase, mitochondrial; MCD
基因别名: AI324784; MCD; MLYCD
UniProt ID: (Human) O95822, (Rat) Q920F5, (Mouse) Q99J39
Entrez Gene ID: (Human) 23417, (Rat) 85239, (Mouse) 56690